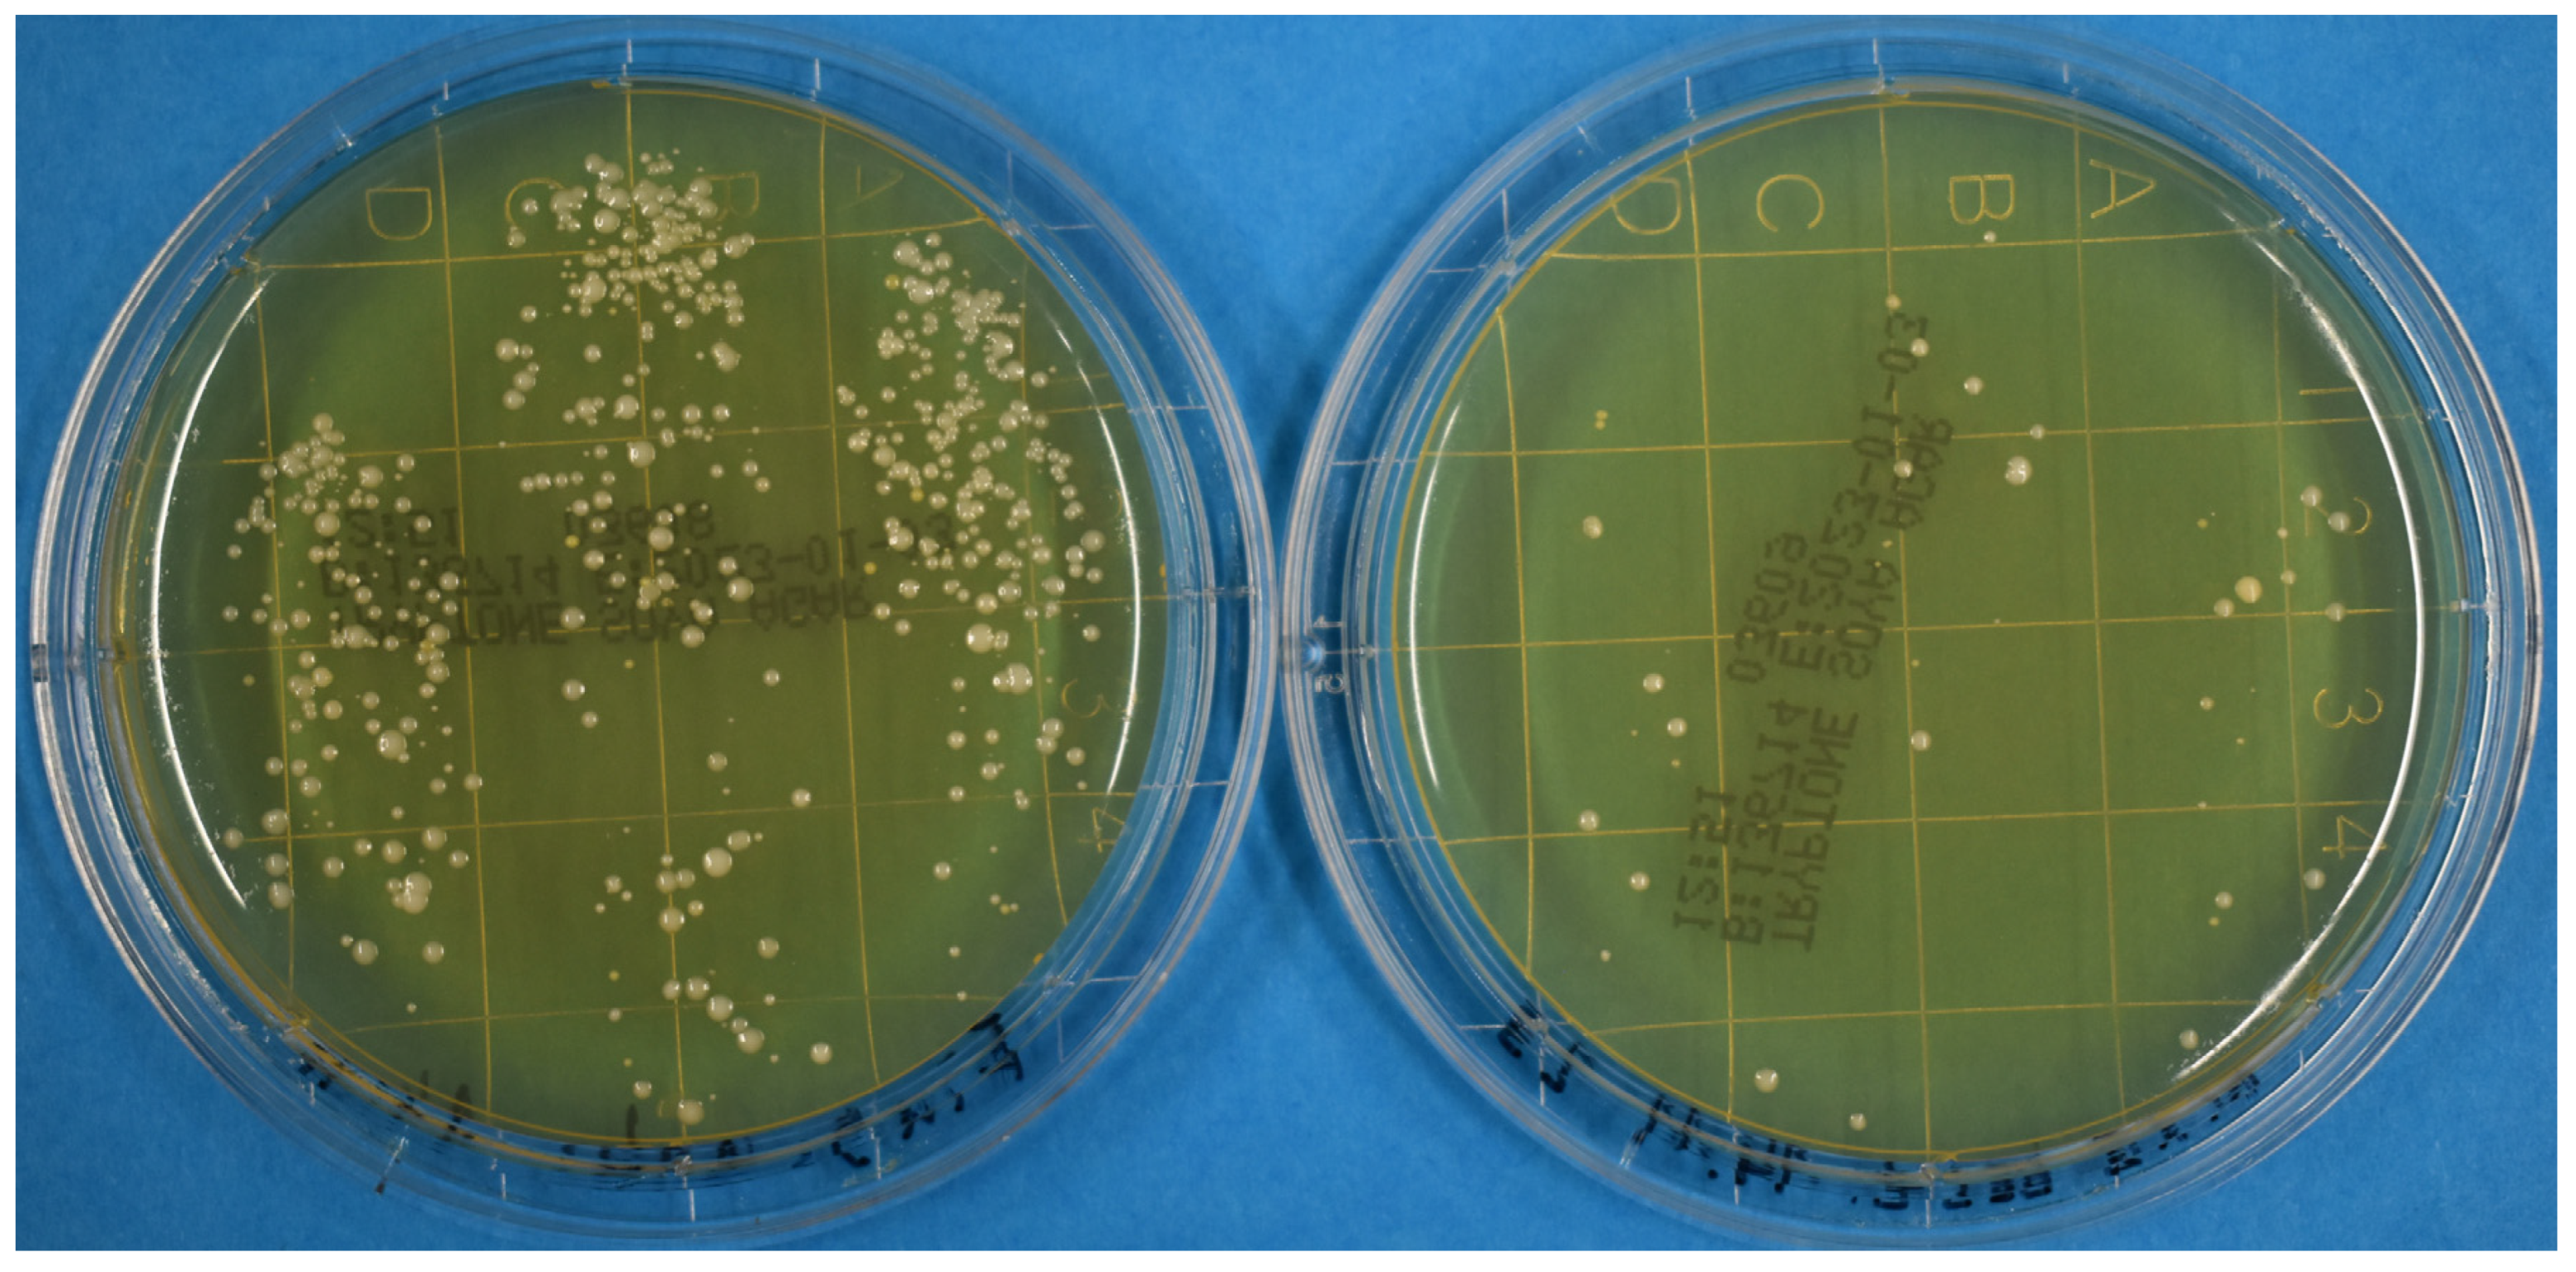
Pathogens 12 00213 g001 Pathogens 12 00213 g001
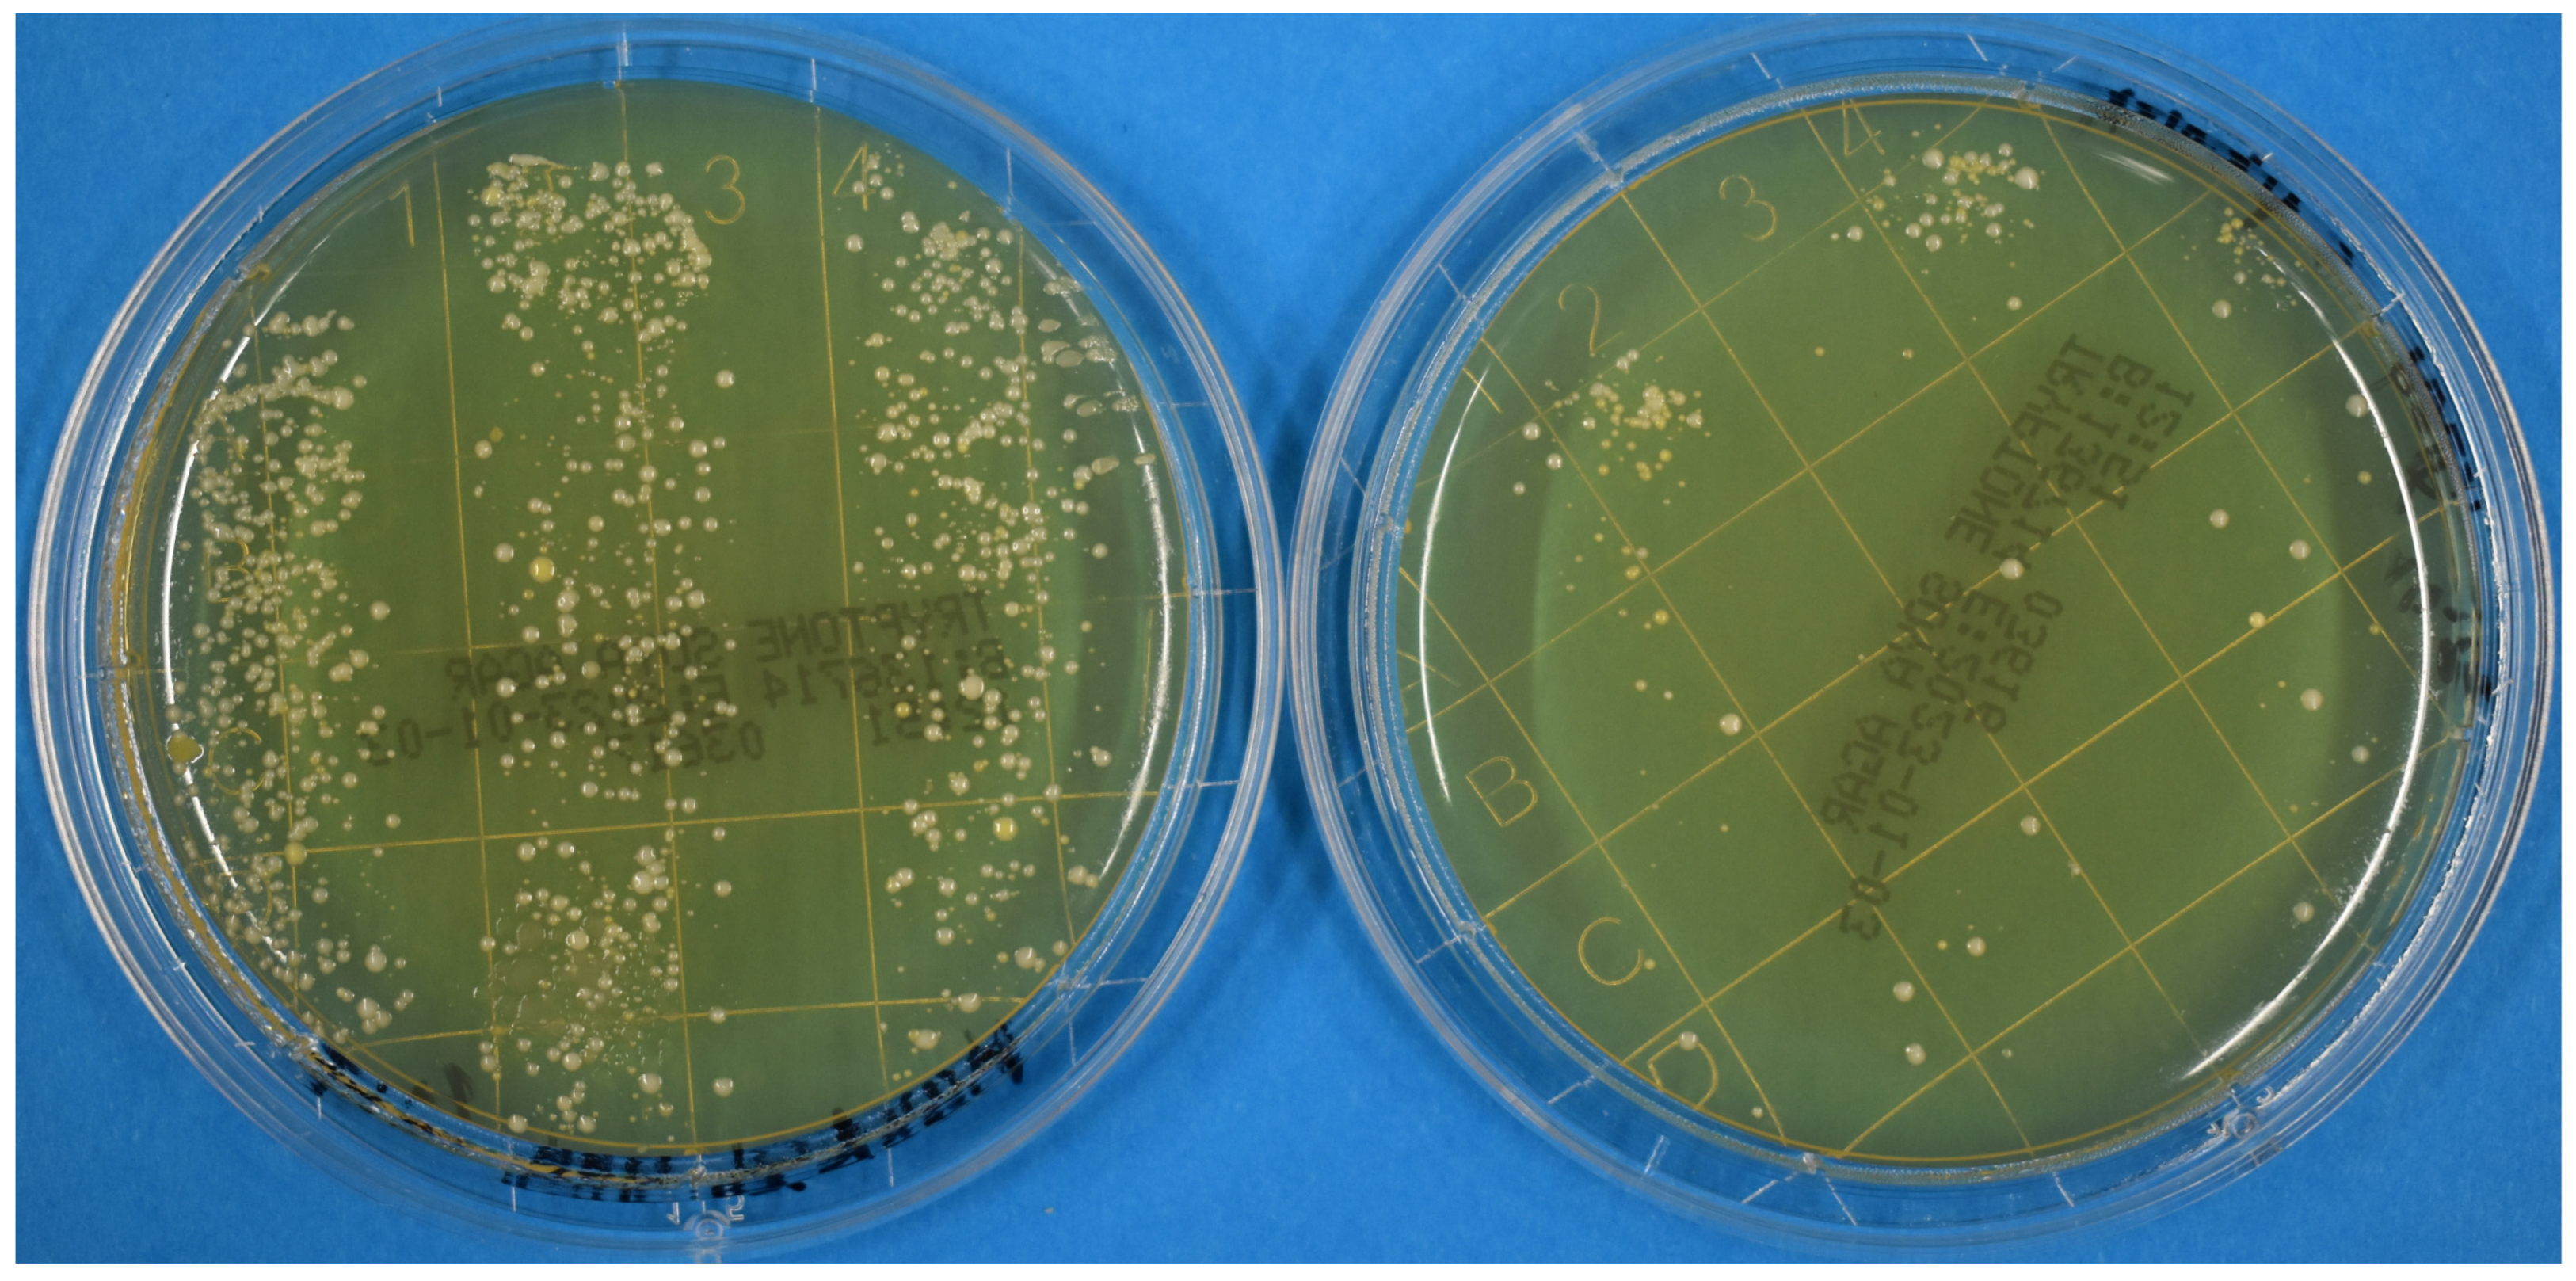
Pathogens 12 00213 g002 Pathogens 12 00213 g002

Far-UVC Radiation for Disinfecting Hands or Gloves?
Abstract
1. Introduction
2. Materials and Methods
3. Results and Discussion
4. Conclusions
Funding
Institutional Review Board Statement
Informed Consent Statement
Data Availability Statement
Conflicts of Interest
References
- Robert, I.K.B. Händehygiene in Einrichtungen des Gesundheitswesens: Empfehlung der Kommission für Krankenhaushygiene und Infektionsprävention (KRINKO) beim Robert Koch-Institut (RKI). Bundesgesundheitsblatt Gesundh. Gesundh. 2016, 59, 1189–1220. [Google Scholar] [CrossRef]
- Stadler, R.N.; Tschudin-Sutter, S. What is new with hand hygiene? Curr. Opin. Infect. Dis. 2020, 33, 327–332. [Google Scholar] [CrossRef] [PubMed]
- Lotfinejad, N.; Peters, A.; Tartari, E.; Fankhauser-Rodriguez, C.; Pires, D.; Pittet, D. Hand hygiene in health care: 20 years of ongoing advances and perspectives. Lancet Infect. Dis. 2021, 21, e209–e221. [Google Scholar] [CrossRef] [PubMed]
- Kramer, A.; Hübner, N.-O.; Assadian, O. Anforderungen an die chirurgische Handedesinfektion und veraendertes Prozedere: Requirements on surgical hand disinfection and modified procedures. GMS Krankenh. Interdiszip 2007, 2, 1–11. [Google Scholar]
- Labadie, J.C.; Kampf, G.; Lejeune, B.; Exner, M.; Cottron, O.; Girard, R.; Orlick, M.; Goetz, M.L.; Darbord, J.-C.; Kramer, A. Recommendations for surgical hand disinfection—Requirements, implementation and need for research. A proposal by representatives of the SFHH, DGHM and DGKH for a European discussion. J. Hosp. Infect. 2002, 51, 312–315. [Google Scholar] [CrossRef] [PubMed]
- Sosnin, E.A.; Stoffels, E.; Erofeev, M.V.; Kieft, I.E.; Kunts, S.E. The Effects of UV Irradiation and Gas Plasma Treatment on Living Mammalian Cells and Bacteria: A Comparative Approach. IEEE Trans. Plasma Sci. 2004, 32, 1544–1550. [Google Scholar] [CrossRef]
- Eadie, E.; Barnard, I.; Ibbotson, S.H.; Wood, K. Extreme Exposure to Filtered Far-UVC: A Case Study. Photochem. Photobiol. 2020, 97, 527–531. [Google Scholar] [CrossRef] [PubMed]
- Sliney, D.H.; Stuck, B.E. A Need to Revise Human Exposure Limits for Ultraviolet UV-C Radiation †. Photochem. Photobiol. 2021, 97, 485–492. [Google Scholar] [CrossRef] [PubMed]
- Buonanno, M.; Welch, D.; Brenner, D.J. Exposure of Human Skin Models to KrCl Excimer Lamps: The Impact of Optical Filtering †. Photochem. Photobiol. 2021, 97, 517–523. [Google Scholar] [CrossRef] [PubMed]
- Welch, D.; Aquino de Muro, M.; Buonanno, M.; Brenner, D.J. Wavelength-dependent DNA Photodamage in a 3-D human Skin Model over the Far-UVC and Germicidal UVC Wavelength Ranges from 215 to 255 nm. Photochem. Photobiol. 2022, 98, 1167–1171. [Google Scholar] [CrossRef] [PubMed]
- Welch, D.; Kleiman, N.J.; Arden, P.C.; Kuryla, C.L.; Buonanno, M.; Ponnaiya, B.; Wu, X.; Brenner, D.J. No Evidence of Induced Skin Cancer or Other Skin Abnormalities after Long-Term (66 week) Chronic Exposure to 222-nm Far-UVC Radiation. Photochem. Photobiol. 2022, 99, 168–175. [Google Scholar] [CrossRef] [PubMed]
- Zwicker, P.; Schleusener, J.; Lohan, S.B.; Busch, L.; Sicher, C.; Einfeldt, S.; Kneissl, M.; Kühl, A.A.; Keck, C.M.; Witzel, C.; et al. Application of 233 nm far-UVC LEDs for eradication of MRSA and MSSA and risk assessment on skin models. Sci. Rep. 2022, 12, 2587. [Google Scholar] [CrossRef] [PubMed]
- Hickerson, R.P.; Conneely, M.J.; Tsutsumi, S.K.H.; Wood, K.; Jackson, D.N.; Ibbotson, S.H.; Eadie, E. Minimal, superficial DNA damage in human skin from filtered far-ultraviolet C. Br. J. Dermatol. 2021, 184, 1197–1199. [Google Scholar] [CrossRef] [PubMed]
- Hessling, M.; Haag, R.; Sieber, N.; Vatter, P. The impact of far-UVC radiation (200–230 nm) on pathogens, cells, skin, and eyes—A collection and analysis of a hundred years of data. GMS Hyg. Infect. Control 2021, 16, Doc07. [Google Scholar] [CrossRef] [PubMed]
- Narita, K.; Asano, K.; Yamane, K.; Ohashi, H.; Igarashi, T.; Nakane, A. Effect of ultraviolet C emitted from KrCl excimer lamp with or without bandpass filter to mouse epidermis. PLoS ONE 2022, 17, e0267957. [Google Scholar] [CrossRef] [PubMed]
- Yamano, N.; Kunisada, M.; Kaidzu, S.; Sugihara, K.; Nishiaki-Sawada, A.; Ohashi, H.; Yoshioka, A.; Igarashi, T.; Ohira, A.; Tanito, M.; et al. Long-term Effects of 222-nm ultraviolet radiation C Sterilizing Lamps on Mice Susceptible to Ultraviolet Radiation. Photochem. Photobiol. 2020, 96, 853–862. [Google Scholar] [CrossRef] [PubMed]
- The European Parliament and the Council of the European Union. Directive 2006/25/EC of the European Parliament and of the Council on the minimum health and safety requirements regarding the exposure of workers to risks arising from physical agents (artificial optical radiation). Off. J. Eur. Union 2006, L114, 38–59. [Google Scholar]
- Strahlenschutzkommission. Jahresbericht 2021 der Strahlenschutzkommission; Strahlenschutzkommission: Bonn, Germany, 2022; Available online: https://www.ssk.de/SharedDocs/Veroeffentlichungen_PDF/JahresberichtederSSK/Jahresbericht_2021.pdf?__blob=publicationFile (accessed on 22 January 2023).
- American Conference of Governmental Industrial Hygienists. 2022 Threshold Limit Values (TLVs) and Biological Exposure Indices (BEIs); ACGIH: Cincinnati, OH, USA, 2022; ISBN 978-1-607261-52-0. Available online: https://www.techstreet.com/standards/2022-threshold-limit-values-tlvs-and-biological-exposure-indices-beis?product_id=2242171#jumps (accessed on 22 January 2023).
- Gierke, A.-M.; Hessling, M. Investigation on Potential ESKAPE Surrogates for 222 and 254 nm Irradiation Experiments. Front. Microbiol. 2022, 13, 942708. [Google Scholar] [CrossRef] [PubMed]
- Weyersberg, L.; Klemens, E.; Buehler, J.; Vatter, P.; Hessling, M. UVC, UVB and UVA susceptibility of Phi6 and its suitability as a SARS-CoV-2 surrogate. AIMS Microbiol. 2022, 8, 279–292. [Google Scholar] [CrossRef] [PubMed]
- WHO. How to Handrub? With Alcohol-Based Formulation. Available online: https://www.youtube.com/watch?v=ZnSjFr6J9HI (accessed on 30 December 2022).
- Srigley, J.A.; Gardam, M.; Fernie, G.; Lightfoot, D.; Lebovic, G.; Muller, M.P. Hand hygiene monitoring technology: A systematic review of efficacy. J. Hosp. Infect. 2015, 89, 51–60. [Google Scholar] [CrossRef] [PubMed]

Disclaimer/Publisher’s Note: The statements, opinions and data contained in all publications are solely those of the individual author(s) and contributor(s) and not of MDPI and/or the editor(s). MDPI and/or the editor(s) disclaim responsibility for any injury to people or property resulting from any ideas, methods, instructions or products referred to in the content. |
© 2023 by the authors. Licensee MDPI, Basel, Switzerland. This article is an open access article distributed under the terms and conditions of the Creative Commons Attribution (CC BY) license (https://creativecommons.org/licenses/by/4.0/).
Share and Cite
Hessling, M.; Sicks, B.; Lau, B. Far-UVC Radiation for Disinfecting Hands or Gloves? Pathogens 2023, 12, 213. https://doi.org/10.3390/pathogens12020213
Hessling M, Sicks B, Lau B. Far-UVC Radiation for Disinfecting Hands or Gloves? Pathogens. 2023; 12(2):213. https://doi.org/10.3390/pathogens12020213
Chicago/Turabian StyleHessling, Martin, Ben Sicks, and Bernhard Lau. 2023. "Far-UVC Radiation for Disinfecting Hands or Gloves?" Pathogens 12, no. 2: 213. https://doi.org/10.3390/pathogens12020213
APA StyleHessling, M., Sicks, B., & Lau, B. (2023). Far-UVC Radiation for Disinfecting Hands or Gloves? Pathogens, 12(2), 213. https://doi.org/10.3390/pathogens12020213





